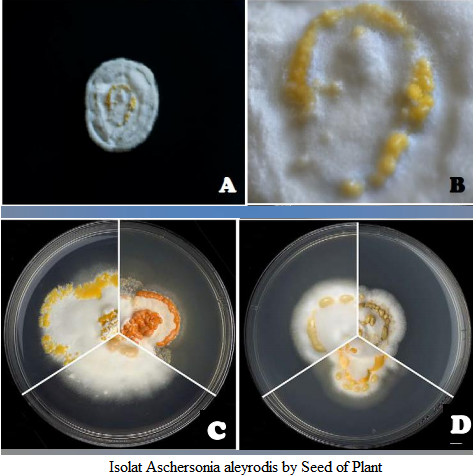
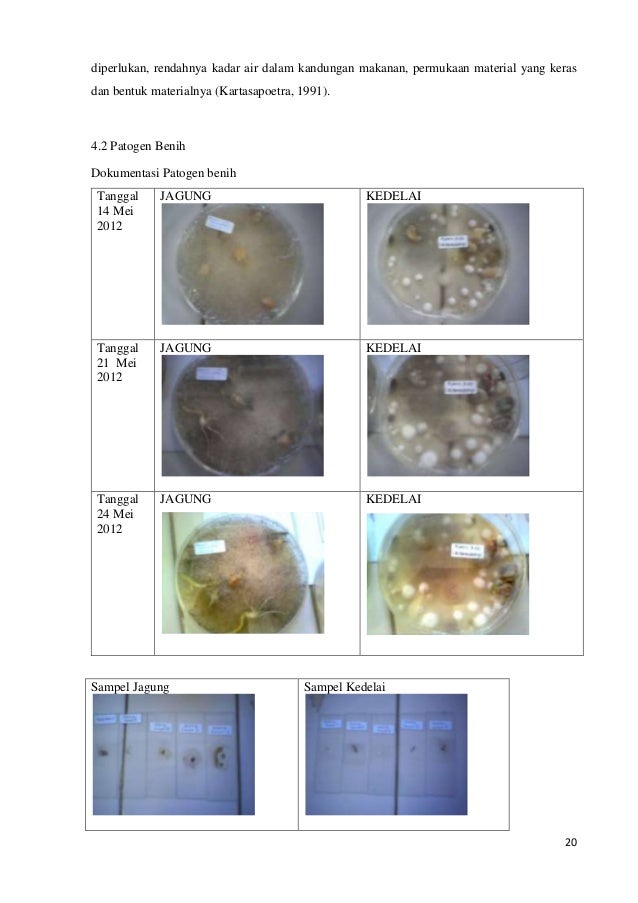

Benih Cendawan In English

Cendawan ini juga mempunyai jumlah tenaga yang amat rendah iaitu lima cendawan butang bersaiz sederhana bersamaan hanya 20 kalori.
Benih cendawan in english. Cendawan entomopatogen termasuk dalam enam kelompok mikroorganisme yang dapat dimanfaatkan sebagai bioinsektisida yaitu cendawan bakteri virus nematoda protozoa dan ricketsia. Benih cendawan mekah mud mud semenyih. Benih cendawan ini sangat mahal harganya sesuai dengan khasiatnya untuk menyembuhkan pelbagai jenis penyakit. Cendawan entomopatogen merupakan salah satu jenis bioinsektisida yang dapat digunakan untuk mengendalikan hama tanaman.
Ia dipanggil dengan pelbagai nama seperti tea combuchea di indonesia alga mekah. Benih cendawan mekah kangar. Cendawan yang mentah bebas kolesterol lemak dan natrium. Benih benih diambil dari botol botol sterill yang telah dipastikan kualiti benih.
Di malaysia cendawan kukur dari pokok kayu getah merupakan jenis yang paling popular di kutip untuk dijadikan bahan makanan yang sangat enak dan berkhasiat. Ini kerana rasanya yang enak dan juga penanaman yang mudah serta sebagai varieti kepada cendawan yang sedia ada. Boleh hubungi kami melalui w s 0123611528 atau boleh pm kami. Keluarga cendawan schizophylaceae mempunyai banyak spesis yang tumbuh pada batang kayu untuk proses pereputan.
Cendawan ini mengandungi vitamin b dan kalium yang tinggi. Cendawan kukur schizophyllum commune adalah sejenis cendawan pada kayu reput dari keluarga schizophylaceae. 1 260 likes 6 talking about this. 7 441 sukaan 19 berbicara tentang ini.
Nak benihcendawanmekah benih cendawan mekah mut mut sekali bekas tidak perlu beli bekas cari bekas. Benih tersebut dimasukkan kedalam setiap bungkah yang telah dikukus telah sejuk dan kemudian disimpan dalam rumah cendawan. Pembekal bongkah benih cendawan tiram. Sama seperti epal dan ubi kentang cendawan ini mengoksida dengan cepat apabila terdedah kepada udara.
4 6 pengurusan hasil cendawan hasil cendawan di kutip mengikut jadual dan boleh dijadualkan pengeluarannya. Benih ini menjadi rebutan diseluruh nusantara india asia barat eropah kerana nilai kandungan perubatan yang terkandung dalam air cendawan ajaib ini.